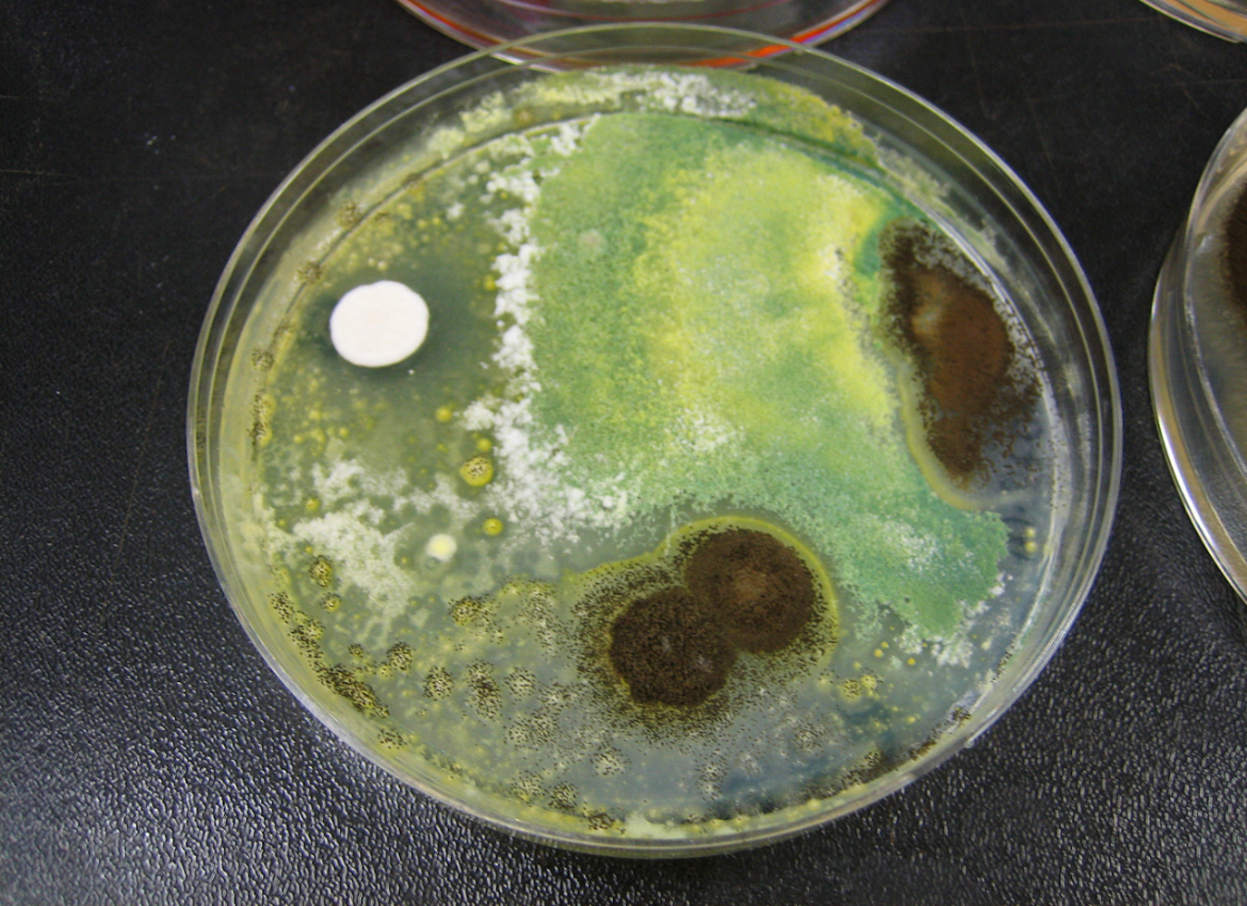

Mycology Laboratory
Photo Source: CDC/ Ginger Chew, Sc.D. (2016)
What We Do
The DSHS Mycology team receives referred isolates of yeast, mold, and aerobic actinomycetes for identification from clinical and reference laboratories across Texas. In-house identification of mycology cultures is based on the macroscopic and microscopic morphology and characteristics of the isolates and their reactions to a panel of biochemical tests. Identification of most molds relies on microscopic morphology. Yeast identification relies on biochemical reactions, MALDI-TOF testing, and microscopic characteristics. Turnaround time for most referred mycological cultures ranges from two to four weeks, depending upon the number of tests required for identification.
For additional information about the yeast, mold, and aerobic actinomycete testing services at the DSHS Austin Laboratory, please contact the Branch Manager at (512) 776-7342.
Testing details for yeast, mold, and aerobic actinomycete specimens may also be found online in the DSHS Laboratory Test Menu.
How to Use This Guide
This specimen submission and shipping guidance is for clinical and reference laboratories who submit referred isolates for identification to the DSHS Austin Laboratory.
The information may be of interest to patients and the public. Those who have health concerns or who seek to submit specimens for analysis are encouraged to discuss those concerns with their healthcare provider. The DSHS laboratory staff cannot make treatment recommendations.
Click on the menu item to quickly navigate to the section of interest.
NOTE
- For information about Candida auris colonization testing at the DSHS Austin Laboratory, please visit the Texas AR Laboratory webpage.
- For information about TB, Hansen’s Disease, and nontuberculous mycobacteria (NTM) testing at the DSHS Austin Laboratory, please visit the Mycobacteriology Lab webpages.
Notices
Austin Laboratory Correspondence and Bulletins
Microbiological Sciences Branch Notices
How to Contact the Mycology Team
Call: Mycology Branch Manager at 512-776-7342
Email: mycobacteriology@dshs.texas.gov